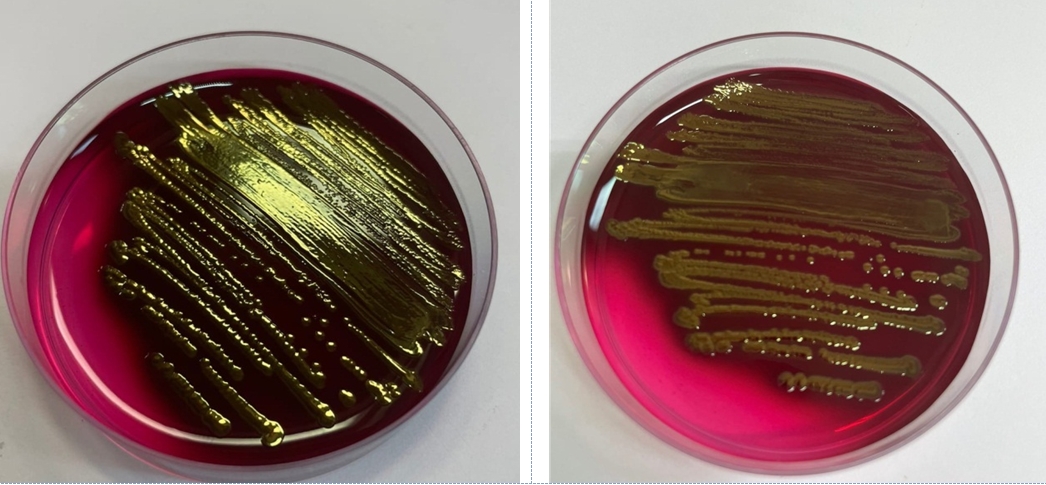
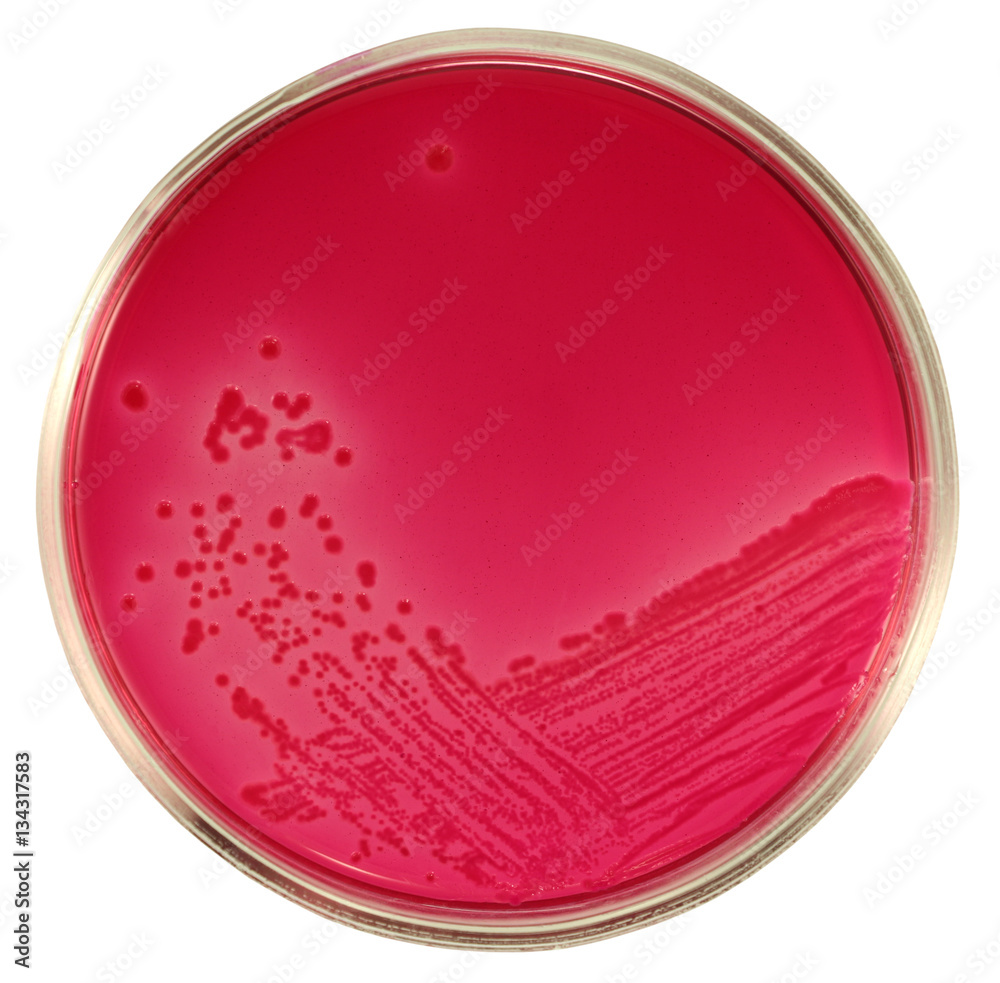

Окраска кишечной палочки
Окраска кишечной палочки 108 фотографий
Делорас интернет магазин детской
Бруну фернандеш футболист
Приманки на судака щуку окуня
Обучение после 7 класса
1 2 флэта
Мопед зид 50 новый
А мы сидим на закате текст
Сколько от железногорска до украины
Читать молитвы джозефа мэрфи на все случаи
Хлорэтан и хлор реакция
Пресноводная губка 6 букв
Демократия научные статьи
Какие поликлиники в калининском районе
Эссенция для коньяка
Проспект ленина 23 ярославль
Молодежь и гаджеты
Петросян шоу самый смешной
Снять комнату в костанае
Рыбацкое 45км
Carina рейка